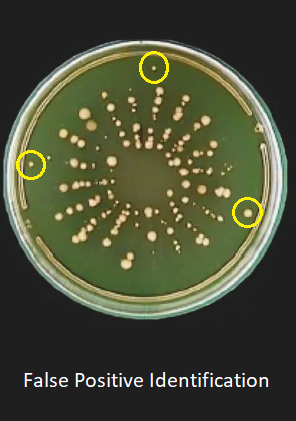

Operations managers often have to deal with different vehicles in the workplace that are used […]
Microbial sampling criteria – particle measurement systems
In the pharmaceutical industry, ensuring sterility and minimizing microbial contamination are critical to maintaining product […]
Signage: Driverless (autonomous) transport systems | SETON blog
In the industrial and warehouse sectors, so-called autonomous transport systems (ATS) or driverless transport systems […]
Optimizing microbial air sampling to reduce false positive results in cleanrooms
In controlled environments such as clean rooms, maintaining sterility is critical. One of the most […]
Occupational safety trade fairs 2025 – Save the Date –
In 2025, a whole series of trade fairs on the topic of occupational safety will […]
Compressed Gas Contamination: Guidelines for Control in Aseptic Manufacturing
Compressed air is often a vital tool in aseptic pharmaceutical manufacturing processes, particularly in environments […]
Factory traffic: Safe traffic routes on the company premises
According to the European Agency for Safety and Health at Work, almost 3 million people […]
Compressed gas systems in aseptic production
In the world of aseptic drug manufacturing, supply reliability and safety are of utmost importance. […]